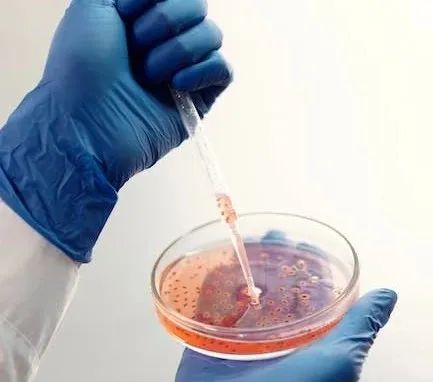

卧薪尝胆:首款口服粪便微生物药物获得FDA批准
注:4月26日,美国FDA批准了Seres Therapeutics公司的一款口服药物,用于治疗18岁以上成人中的复发性艰难梭菌感染(CDI)。这些患者一般都已经接受过抗生素治疗,导致肠道菌失调,之前可通过粪便移植来治疗。
Seres Therapeutics公司的这款药物,由来自粪便的微生物组成,是一款“活细菌”药物。借此机会,重发一篇于2013年左右写的小作文,收录于《吃什么呢?舌尖上的思考》一书。

10年前写的小文
卧薪, 一直以为是睡在用来烧火的柴上。某度后才知道薪是一种苦菜,刺激眼睛,提神的。
尝胆,看了连续剧之后知道,尝的是污秽之物。古人说话为什么就不能直白一点,尤其在教人励志的时候?真的是不想让人复制成功?
以前听说童子尿可以做药引治什么什么病,但那是坊间的偏方。现在有医学实验说明污秽之物可以用来治病。但是,不是用来尝的。
纽约时报上报道,有一个慢性腹泻患者,病情非常严重,用了若干抗菌素都控制不住腹泻,八个月掉了60磅。明尼苏达大学医学中心的“可如此”可大夫(Dr. Khoruts), 决定兵行险招,给患者下点猛药,来点污秽之物。
要是一蒙古大夫,可能也就让患者口服了。“可如此”大夫做的是移植,用的是患者丈夫的污秽之物,生理盐水混匀后直接移入患者直肠。
一天之后,腹泻停封了。
中医里有缺什么补什么之说。慢性腹泻,每天要排泄出很多污秽之物。可大夫绝对不是出于缺什么补什么的考量,给患者补污秽之物。患者也不是随随便便找了一个江湖郎中,而是在正规医院治疗了数月无效之后才不得以而为之。患者的病因是一种超级恶劣的肠道细菌——艰难梭菌(Clostridium difficile)的过度繁殖。
这种被称为“粪菌移植”的肠道菌群治病方法,于2013年写入美国艰难梭菌感染的临床治疗指南(CPT code 44705)。但是有人提出,中国早在东晋时期(公元300-400年)葛洪所著的《肘后备急方》里,就有粪便治疗人类疾病的文字记载。葛洪的这本奇书,里面有很多荒诞不经的东西,也有一些有价值的资料,屠呦呦从《肘后备急方》中挖出了治疗疟疾的青蒿素,最终于2012年获得美国拉斯克临床医学奖。
《肘后备急方》里相关的粪便疗法,应该是中医里的“黄龙汤”,其实就是粪水埋于地下发酵而制。但是葛洪描述的这个方子,不一定是中国原创。范文澜的《 中国通史》记载,黄龙汤是汉代由天竺传入,属于古印度的医药。此外,黄龙汤是用来治疗瘟疫的,我个人怀疑是古代人基于“污秽之物可除邪”的无可奈何之举措。
而“粪菌移植”的目的,是重建人体的肠道菌群平衡。艰难梭菌多为医院中感染,引起肠炎。根据美国疾病控制中心的资料,由艰难梭菌感染导致的死亡,从2000年到 2007年间增加了四倍,现估计每年要死亡一万四千人。这个细菌能在医院里广泛传播,是因为大量抗菌素的使用,不但杀不死这种菌,反而因为把其他细菌杀死,让这种艰难梭菌有更多的机会大肆扩增。
可大夫在粪菌移植手术两星期后,检查发现患者的肠道已经被正常菌覆盖了。这真是以菌制菌,也可以说是以毒攻毒的范例。
这就是医学上的无间道,本来是治病的药(抗菌素),可能也会带来伤害;本来是觉得有害的细菌,却可能用来救人!
时间快进10年>>
瑞士一家药企(Ferring Pharmaceuticals)的粪便移植,之前已经获批上市,但是需要通过肛门灌肠给药。虽然也是治病救人之举,但是患者的尊严需要随着裤子脱下,低到了尘埃。
Seres Therapeutics公司“活细菌”药物SER-109,由多种厚壁菌门菌种的纯化细菌孢子组成。这些微生物在调节艰难梭菌生命周期和CDI疾病发生方面具有重要作用。在1b期临床试验中,高达86.7%的CDI患者使用SER-109治疗之后达到试验主要终点,SER-109也获得美国FDA的“突破性疗法”认定。
但是,在2期临床试验中,SER-109却受到挫折。在接受SER-109治疗8周后,与对照组相比,患者CDI复发风险并未显著降低。
但SER-109并未完全失败。对临床试验数据的分析发现,误诊和用药剂量不足可能是导致试验结果不理想的原因。Seres Therapeutics公司也经历了“卧薪尝胆”的过程,进行了公司重组,甚至在2019年不得不裁员30%,将资源集中于少数几个关键项目。在关键性3期临床试验中,SER-109达到主要终点:接受治疗8周后,SER-109组CDI患者的复发率为12.4%,而安慰剂患者为39.8%。与安慰剂组相比,SER-109治疗组的疾病复发风险降低了68% (HR 0.32, 95% CI,0.18,0.58)。
与粪便移植相比,患者应该更容易接受如今获批的口服“活细菌”。有预测认为,该药物在美国的上市价格可能是2万美金一个疗程,在2033年,美国市场销售峰值可达7.5亿美金。
如果生病了,大家会愿意花2万美金买一个来自粪便的药物吗?粪便可能不是问题,由于有传统文化,国人对于粪便的接受度还是很高的。
但是,有没有这2万美金,却可能是一个问题。
发表评论





暂时没有评论,来抢沙发吧~